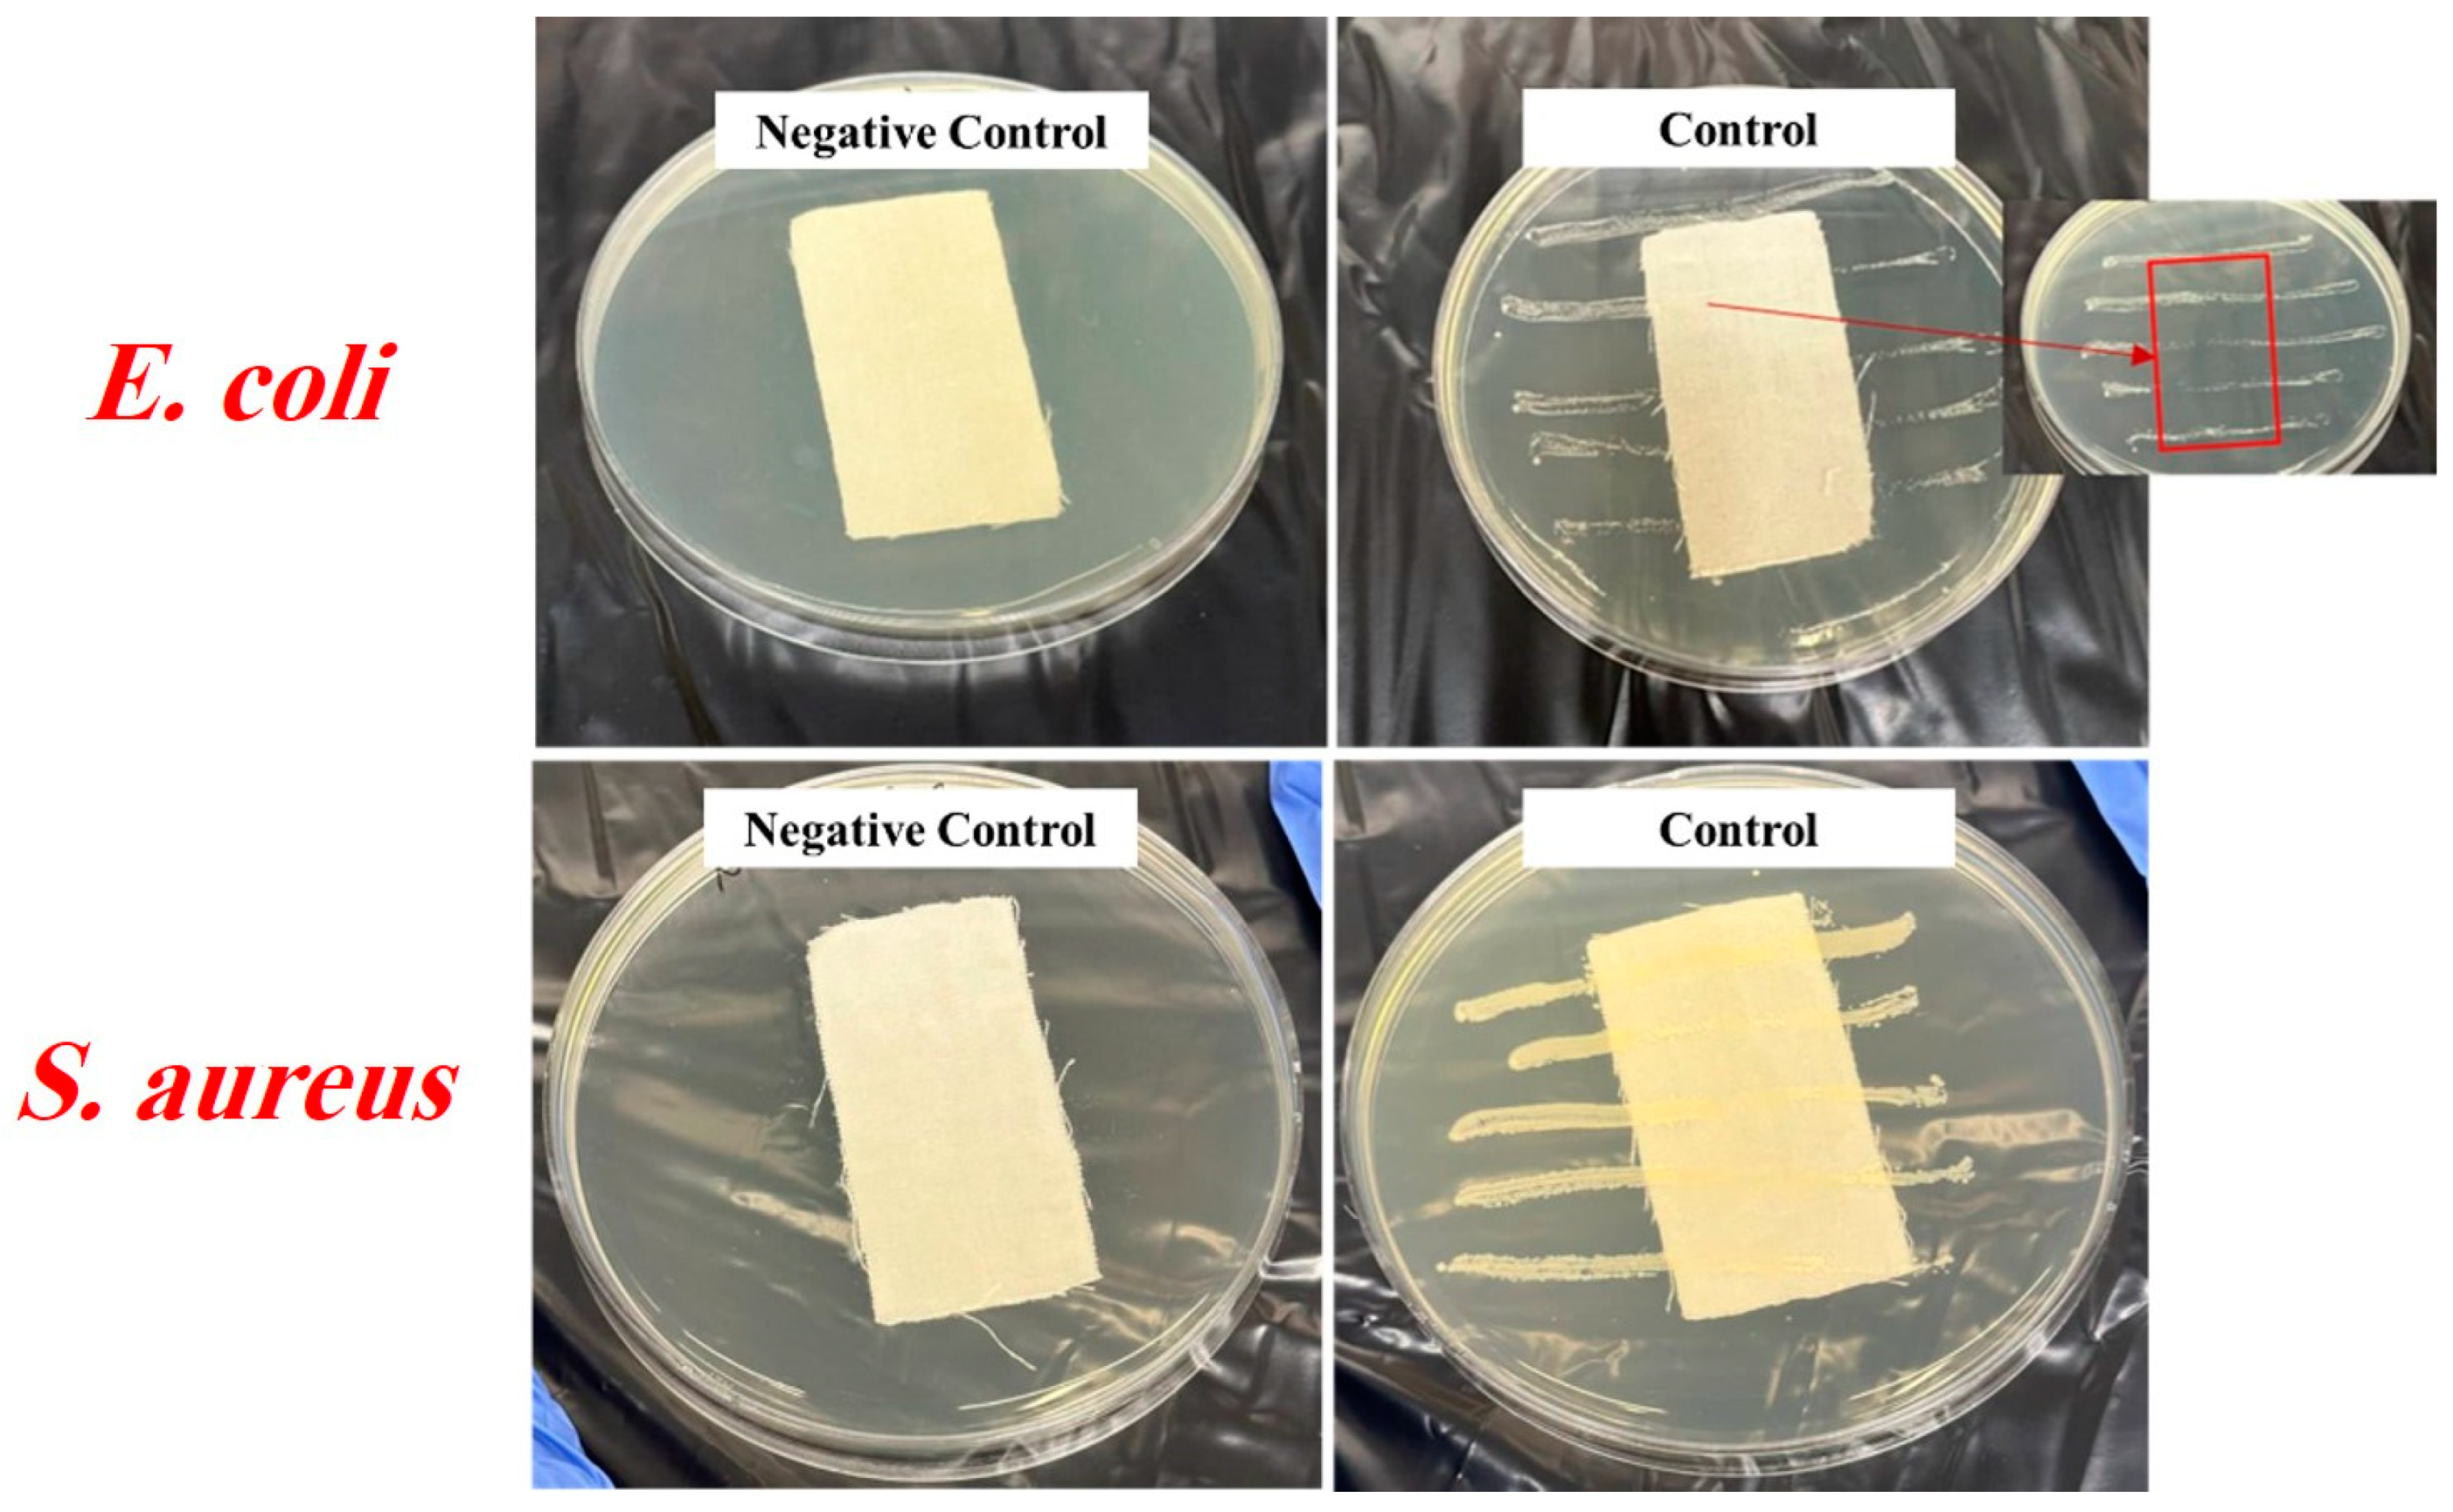
Gels 10 00398 g007
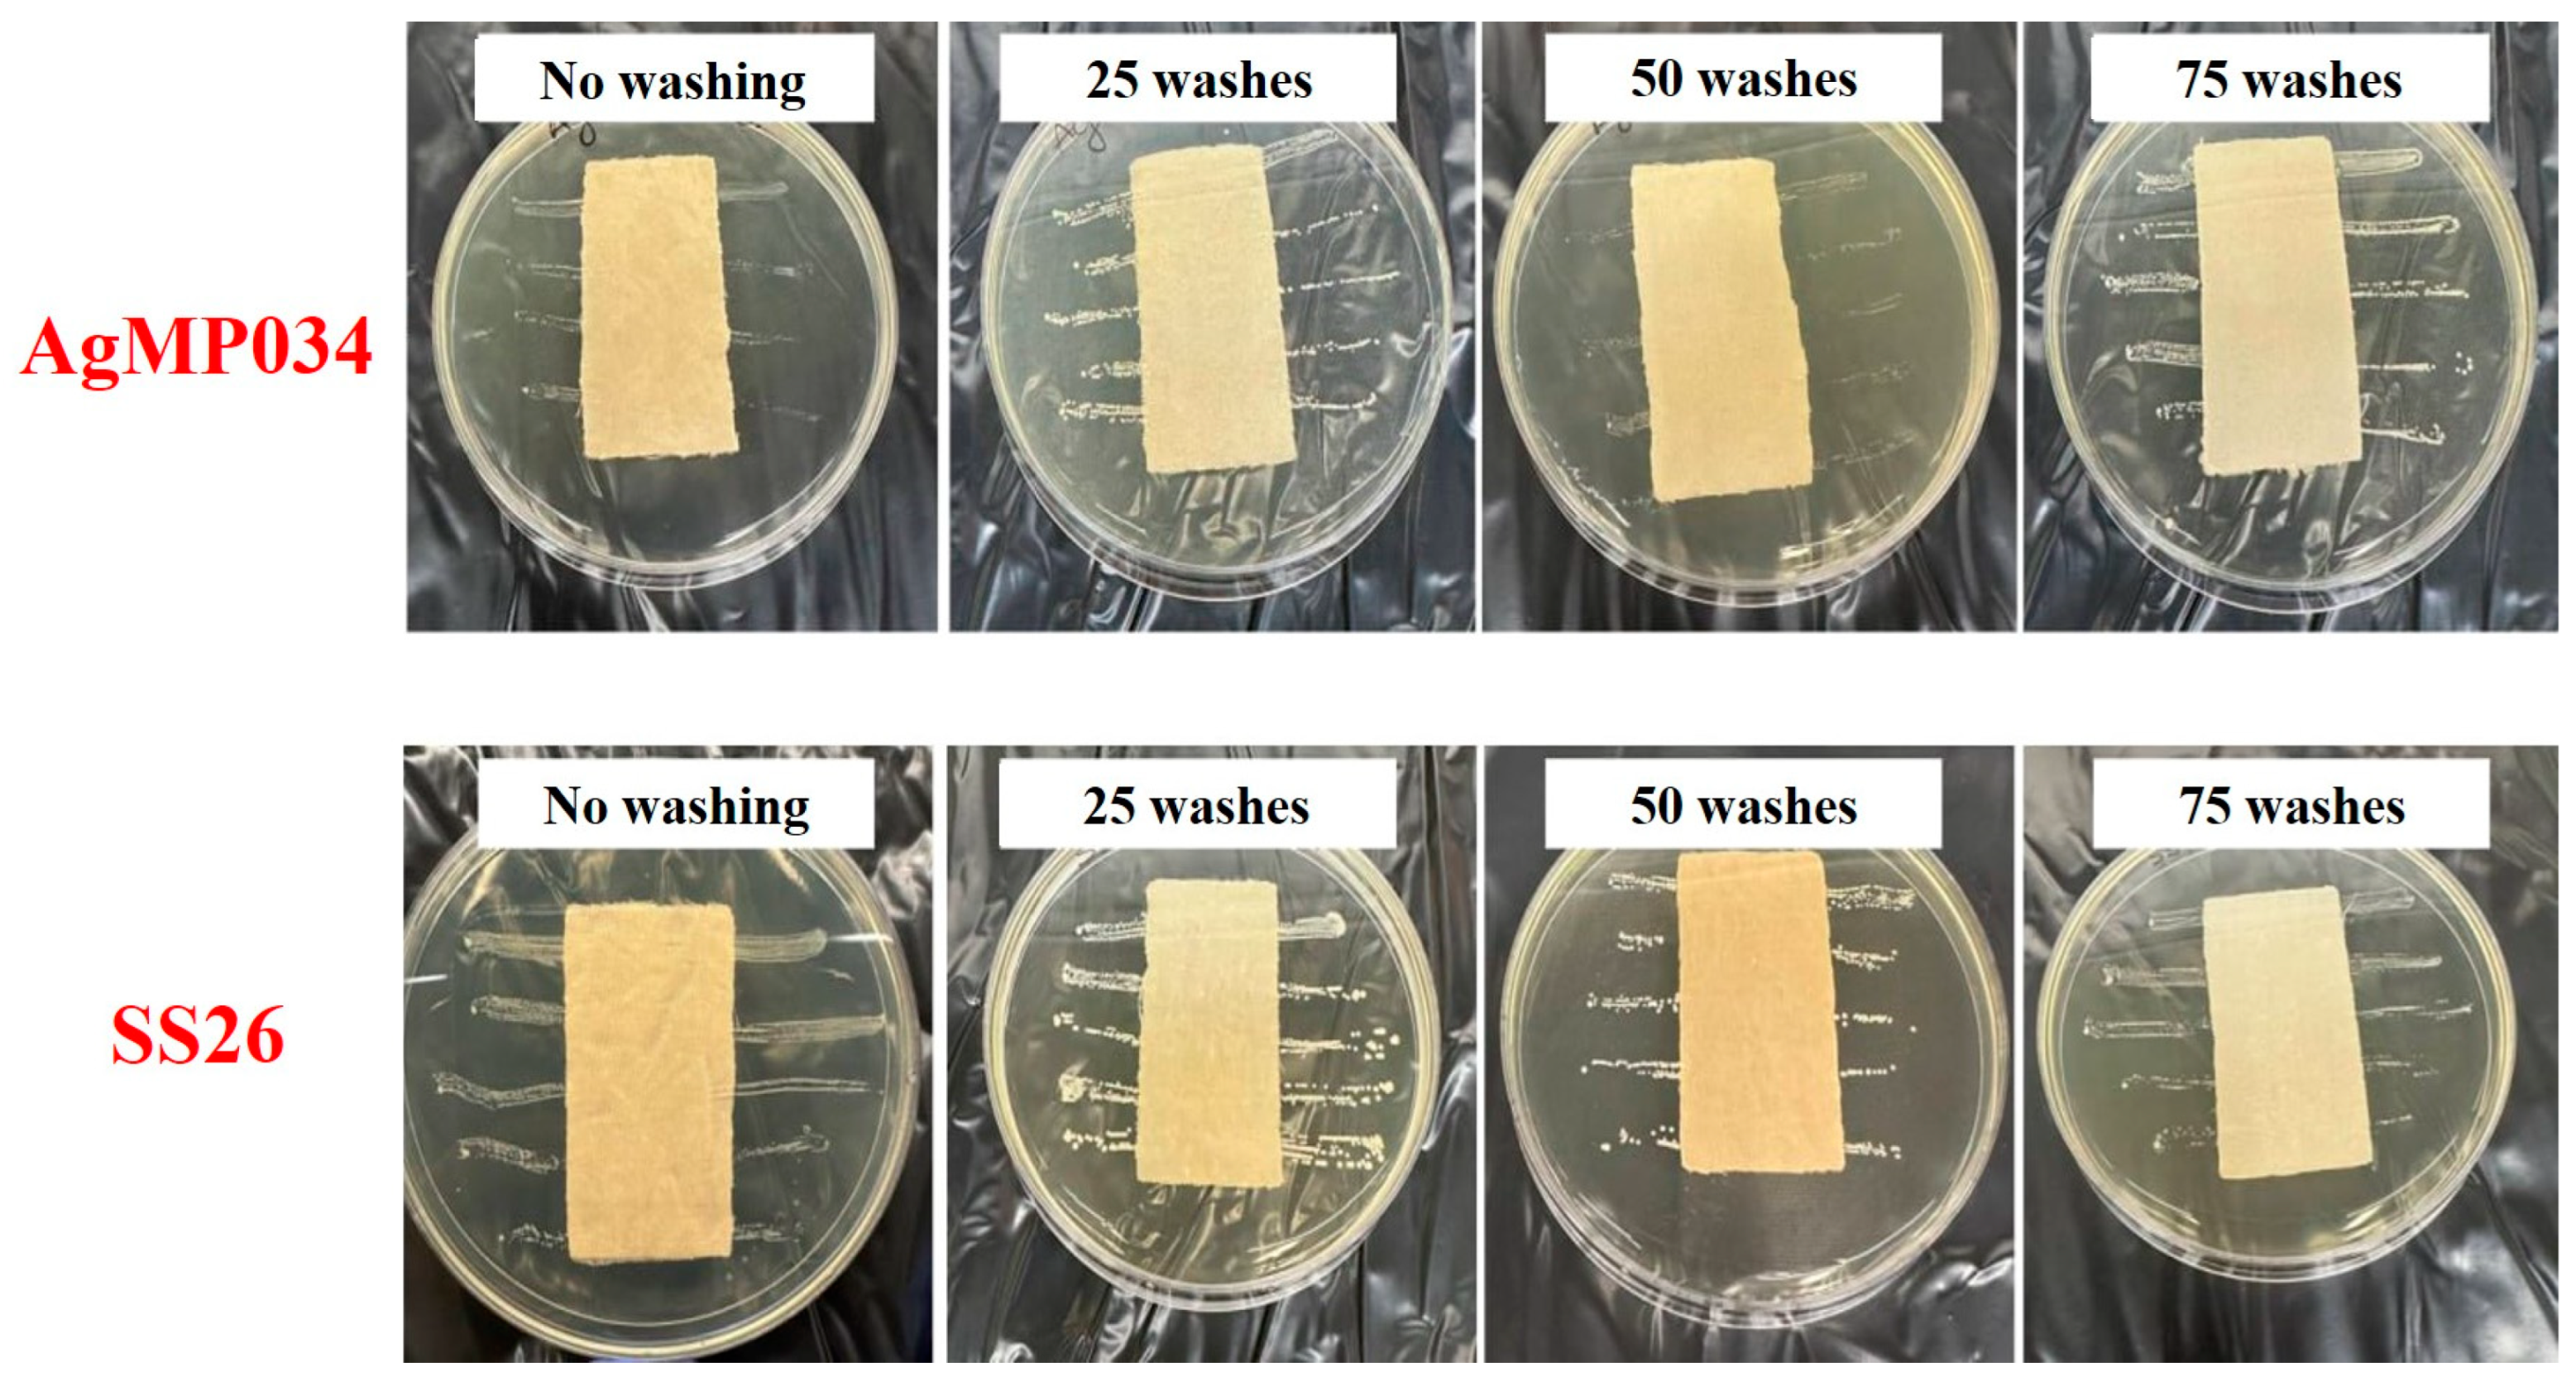
Gels 10 00398 g009
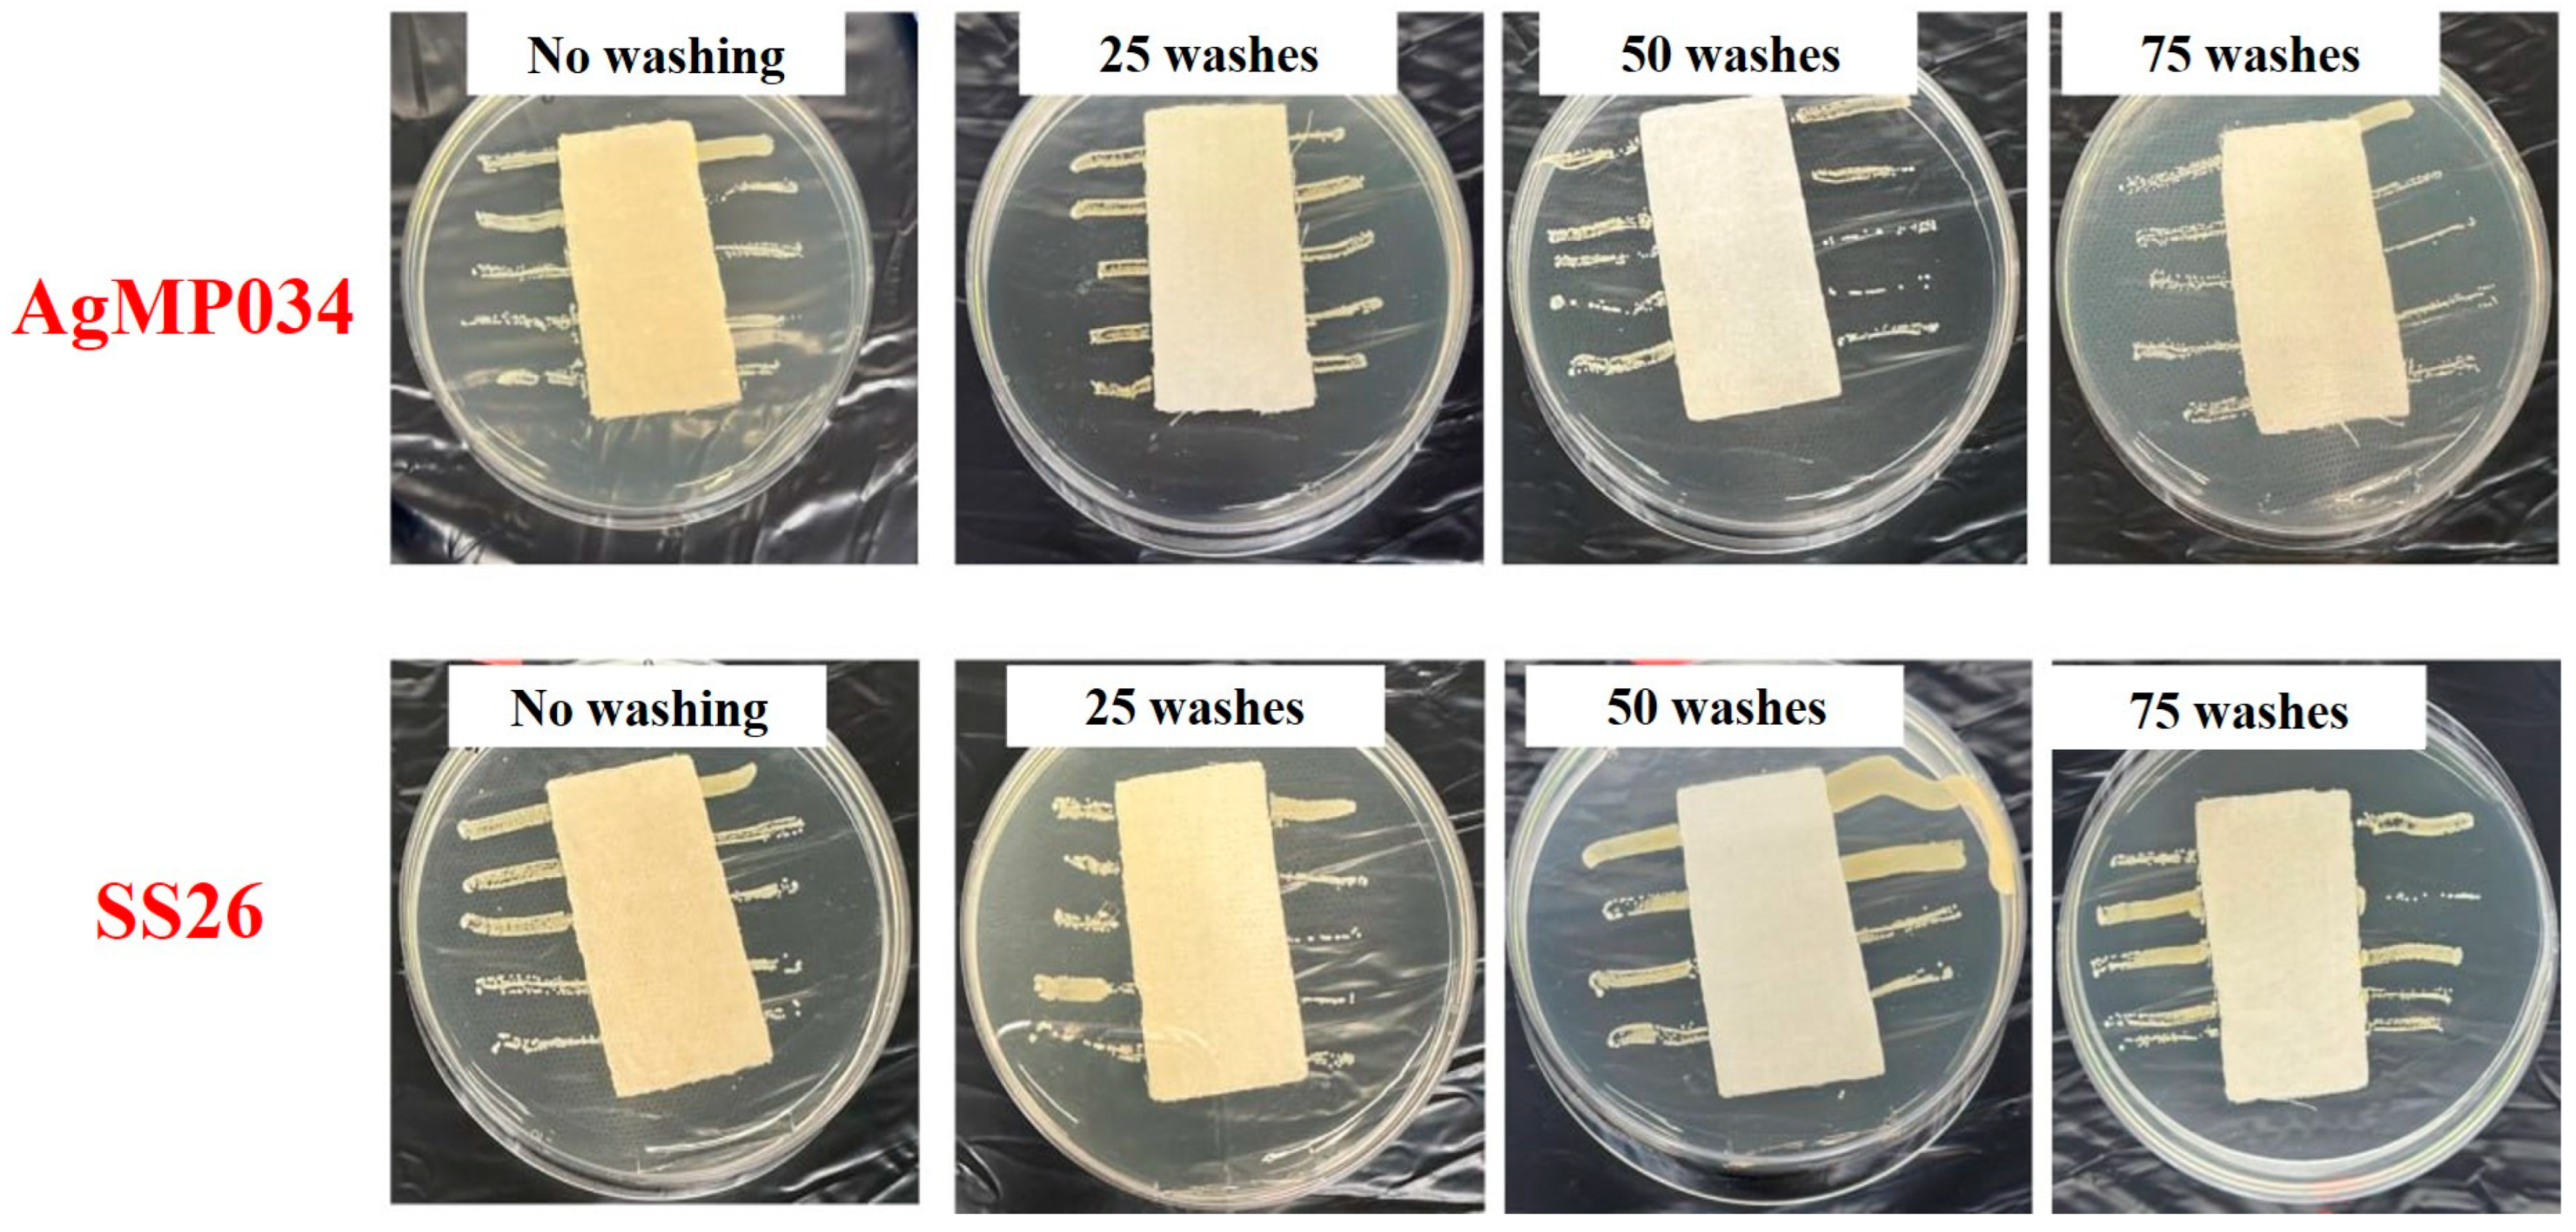
Gels 10 00398 g010

The Highly Durable Antibacterial Gel-like Coatings for Textiles
Abstract
1. Introduction
2. Results and Discussion
2.1. Silver Shell™ Solution Characterization
2.2. Coating Characterization
2.3. Antibacterial Studies
2.4. Bactericidal Action against Multidrug-Resistant E. coli Strains
2.5. Color Measurement Study
3. Conclusions
4. Materials and Methods
4.1. Materials
4.2. Characterization of Silver Shell™ Solutions
4.3. Coating Procedure
4.4. Characterization of Coated Fabrics
4.4.1. Surface Morphology
4.4.2. Color Measurements
4.4.3. Antimicrobial Fabric Test
Author Contributions
Funding
Institutional Review Board Statement
Informed Consent Statement
Data Availability Statement
Conflicts of Interest
References
- Jena, P.; Mohanty, S.; Mallick, R.; Jacob, B.; Sonawane, A. Toxicity and antibacterial assessment of chitosan-coated silver nanoparticles on human pathogens and macrophage cells. Int. J. Nanomed. 2012, 7, 1805–1818. [Google Scholar] [CrossRef]
- Canama, G.J.C.; Delco, M.C.L.; Talandron, R.A.; Tan, N.P. Synthesis of Chitosan-Silver Nanocomposite and Its Evaluation as an Antibacterial Coating for Mobile Phone Glass Protectors. ACS Omega 2023, 8, 17699–17711. [Google Scholar] [CrossRef]
- Ikuta, K.S.; Swetschinski, L.R.; Aguilar, G.R.; Sharara, F.; Mestrovic, T.; Gray, A.P.; Weaver, N.D.; E Wool, E.; Han, C.; Hayoon, A.G.; et al. Global mortality associated with 33 bacterial pathogens in 2019: A systematic analysis for the Global Burden of Disease Study 2019. Lancet 2022, 400, 2221–2248. [Google Scholar] [CrossRef]
- Hicks, A.L.; Reed, R.B.; Theis, T.L.; Hanigan, D.; Huling, H.; Zaikova, T.; Hutchison, J.E.; Miller, J. Environmental impacts of reusable nanoscale silver-coated hospital gowns compared to single-use, disposable gowns. Environ. Sci. Nano 2016, 3, 1124–1132. [Google Scholar] [CrossRef]
- Gonçalves, R.A.; Ku, J.W.K.; Zhang, H.; Salim, T.; Oo, G.; Zinn, A.A.; Boothroyd, C.; Tang, R.M.Y.; Gan, C.L.; Gan, Y.-H.; et al. Copper-Nanoparticle-Coated Fabrics for Rapid and Sustained Antibacterial Activity Applications. ACS Appl. Nano Mater. 2022, 5, 12876–12886. [Google Scholar] [CrossRef]
- Qiu, H.; Si, Z.; Luo, Y.; Feng, P.; Wu, X.; Hou, W.; Zhu, Y.; Chan-Park, M.B.; Xu, L.; Huang, D. The mechanisms and the applications of antibacterial polymers in surface modification on medical devices. Front. Bioeng. Biotechnol. 2020, 8, 910. [Google Scholar] [CrossRef]
- Balakumaran, M.D.; Ramachandran, R.; Jagadeeswari, S.; Kalaichelvan, P.T. In vitro biological properties and characterization of nanosilver coated cotton fabrics—An application for antimicrobial textile finishing. Int. Biodeterior. Biodegrad. 2016, 107, 48–55. [Google Scholar] [CrossRef]
- Botelho, C.M.; Fernandes, M.M.; Souza, J.M.; Dias, N.; Sousa, A.M.; Teixeira, J.A.; Fangueiro, R.; Zille, A. New textile for personal protective equipment—Plasma chitosan/silver nanoparticles nylon fabric. Fibers 2021, 9, 3. [Google Scholar] [CrossRef]
- El-Rafie, M.; Ahmed, H.B.; Zahran, M. Characterization of nanosilver coated cotton fabrics and evaluation of its antibacterial efficacy. Carbohydr. Polym. 2014, 107, 174–181. [Google Scholar] [CrossRef]
- Gadkari, R.R.; Ali, S.W.; Joshi, M.; Rajendran, S.; Das, A.; Alagirusamy, R. Leveraging antibacterial efficacy of silver loaded chitosan nanoparticles on layer-by-layer self-assembled coated cotton fabric. Int. J. Biol. Macromol. 2020, 162, 548–560. [Google Scholar] [CrossRef] [PubMed]
- Petkova, P.; Francesko, A.; Perelshtein, I.; Gedanken, A.; Tzanov, T. Simultaneous sonochemical-enzymatic coating of medical textiles with antibacterial ZnO nanoparticles. Ultrason. Sonochemistry 2016, 29, 244–250. [Google Scholar] [CrossRef] [PubMed]
- Zheng, Y.; Xiao, M.; Jiang, S.; Ding, F.; Wang, J. Coating fabrics with gold nanorods for colouring, UV-protection, and antibacterial functions. Nanoscale 2013, 5, 788–795. [Google Scholar] [CrossRef]
- El-Naggar, M.E.; Shaarawy, S.; Hebeish, A. Bactericidal finishing of loomstate, scoured and bleached cotton fibres via sustainable in-situ synthesis of silver nanoparticles. Int. J. Biol. Macromol. 2018, 106, 1192–1202. [Google Scholar] [CrossRef]
- Shcherbakov, A.B.; Reukov, V.V.; Yakimansky, A.V.; Krasnopeeva, E.L.; Ivanova, O.S.; Popov, A.L.; Ivanov, V.K. CeO2 nanoparticle-containing polymers for biomedical applications: A review. Polymers 2021, 13, 924. [Google Scholar] [CrossRef]
- Qian, J.; Dong, Q.; Chun, K.; Zhu, D.; Zhang, X.; Mao, Y.; Culver, J.N.; Tai, S.; German, J.R.; Dean, D.P.; et al. Highly stable, antiviral, antibacterial cotton textiles via molecular engineering. Nat. Nanotechnol. 2023, 18, 168–176. [Google Scholar] [CrossRef]
- Gulati, R.; Sharma, S.; Sharma, R.K. Antimicrobial textile: Recent developments and functional perspective. Polym. Bull. 2022, 79, 5747–5771. [Google Scholar] [CrossRef]
- Li, Y.; Miao, Q.; Wang, X. Antibacterial capability of air filter fiber materials treated with triclosan against indoor environmental microbes. Atmosphere 2022, 13, 1104. [Google Scholar] [CrossRef]
- Shrestha, P.; Zhang, Y.; Chen, W.J.; Wong, T.Y. Triclosan: Antimicrobial mechanisms, antibiotics interactions, clinical applications, and human health. J. Environ. Sci. Health Part C 2020, 38, 245–268. [Google Scholar] [CrossRef]
- Qian, L.; Sun, G. Durable and regenerable antimicrobial textiles: Improving efficacy and durability of biocidal functions. J. Appl. Polym. Sci. 2004, 91, 2588–2593. [Google Scholar] [CrossRef]
- Ma, Y.; Aslam, M.Z.; Wu, M.; Nitin, N.; Sun, G. Strategies and perspectives of developing anti-biofilm materials for improved food safety. Food Res. Int. 2022, 159, 111543. [Google Scholar] [CrossRef] [PubMed]
- Sun, X.; Zhang, L.; Cao, Z.; Deng, Y.; Liu, L.; Fong, H.; Sun, Y. Electrospun composite nanofiber fabrics containing uniformly dispersed antimicrobial agents as an innovative type of polymeric materials with superior antimicrobial efficacy. ACS Appl. Mater. Interfaces 2010, 2, 952–956. [Google Scholar] [CrossRef]
- Saverina, E.A.; Frolov, N.A.; Kamanina, O.A.; Arlyapov, V.A.; Vereshchagin, A.N.; Ananikov, V.P. From Antibacterial to Antibiofilm Targeting: An Emerging Paradigm Shift in the Development of Quaternary Ammonium Compounds (QACs). ACS Infect. Dis. 2023, 9, 394–422. [Google Scholar] [CrossRef]
- Wang, P.; Zhang, M.; Qu, J.; Wang, L.; Geng, J.; Fu, F.; Liu, X. Antibacterial cotton fabric prepared by a “grafting to” strategy using a QAC copolymer. Cellulose 2022, 29, 3569–3581. [Google Scholar] [CrossRef]
- Yueh, M.-F.; Tukey, R.H. Triclosan: A widespread environmental toxicant with many biological effects. Annu. Rev. Pharmacol. Toxicol. 2016, 56, 251–272. [Google Scholar] [CrossRef]
- Reshma, A.; Priyadarisini, V.; Amutha, K. Sustainable antimicrobial finishing of fabrics using natural bioactive agents—A review. Int. J. Life Sci. Pharma Res. 2018, 8, 10–20. [Google Scholar] [CrossRef]
- Yıldırım, F.F.; Avinc, O.; Yavas, A.; Sevgisunar, G. Sustainable antifungal and antibacterial textiles using natural resources. In Sustainability in the Textile and Apparel Industries: Sourcing Natural Raw Materials; Springer: Cham, Switzerland, 2020; pp. 111–179. [Google Scholar]
- Tanasa, F.; Teaca, C.-A.; Nechifor, M.; Ignat, M.; Duceac, I.A.; Ignat, L. Highly Specialized Textiles with Antimicrobial Functionality—Advances and Challenges. Textiles 2023, 3, 219–245. [Google Scholar] [CrossRef]
- Vertuccio, L.; Guadagno, L.; D’angelo, A.; Viola, V.; Raimondo, M.; Catauro, M. Sol-gel synthesis of caffeic acid entrapped in silica/polyethylene glycol based organic-inorganic hybrids: Drug delivery and biological properties. Appl. Sci. 2023, 13, 2164. [Google Scholar] [CrossRef]
- Catauro, M.; D’Angelo, A.; Fiorentino, M.; Pacifico, S.; Latini, A.; Brutti, S.; Ciprioti, S.V. Thermal, spectroscopic characterization and evaluation of antibacterial and cytotoxicity properties of quercetin-PEG-silica hybrid materials. Ceram. Int. 2023, 49, 14855–14863. [Google Scholar] [CrossRef]
- Tan, L.; Sin, L.T.; Bee, S.; Ratnam, C.T.; Woo, K.; Tee, T.; Rahmat, A.R. A review of antimicrobial fabric containing nanostructures metal-based compound. J. Vinyl Addit. Technol. 2019, 25, E3–E27. [Google Scholar] [CrossRef]
- Sfameni, S.; Hadhri, M.; Rando, G.; Drommi, D.; Rosace, G.; Trovato, V.; Plutino, M.R. Inorganic finishing for textile fabrics: Recent advances in wear-resistant, UV protection and antimicrobial treatments. Inorganics 2023, 11, 19. [Google Scholar] [CrossRef]
- Feng, Q.L.; Wu, J.; Chen, G.Q.; Cui, F.Z.; Kim, T.N.; Kim, J.O. A mechanistic study of the antibacterial effect of silver ions on Escherichia aureus and Staphylococcus aureus. J. Biomed. Mater. Res. 2000, 52, 662–668. [Google Scholar] [CrossRef]
- Yin, I.X.; Zhang, J.; Zhao, I.S.; Mei, M.L.; Li, Q.; Chu, C.H. The antibacterial mechanism of silver nanoparticles and its application in dentistry. Int. J. Nanomed. 2020, 15, 2555–2562. [Google Scholar] [CrossRef] [PubMed]
- Bektas, N.; Şenel, B.; Yenilmez, E.; Özatik, O.; Arslan, R. Evaluation of wound healing effect of chitosan-based gel formulation containing vitexin. Saudi Pharm. J. 2020, 28, 87–94. [Google Scholar] [CrossRef]
- Sánchez, R.; Alonso, G.; Valencia, C.; Franco, J. Rheological and TGA study of acylated chitosan gel-like dispersions in castor oil: Influence of acyl substituent and acylation protocol. Chem. Eng. Res. Des. 2015, 100, 170–178. [Google Scholar] [CrossRef]
- Mohammadi, H.; Alihosseini, F.; Hosseini, S.A. Improving physical and biological properties of nylon monofilament as suture by Chitosan/Hyaluronic acid. Int. J. Biol. Macromol. 2020, 164, 3394–3402. [Google Scholar] [CrossRef]
- Kumar-Krishnan, S.; Prokhorov, E.; Hernández-Iturriaga, M.; Mota-Morales, J.D.; Vázquez-Lepe, M.; Kovalenko, Y.; Sanchez, I.C.; Luna-Bárcenas, G. Chitosan/silver nanocomposites: Synergistic antibacterial action of silver nanoparticles and silver ions. Eur. Polym. J. 2015, 67, 242–251. [Google Scholar] [CrossRef]
- Grgac, S.F.; Tarbuk, A.; Dekanić, T.; Sujka, W.; Draczyński, Z. The chitosan implementation into cotton and polyester/cotton blend fabrics. Materials 2020, 13, 1616. [Google Scholar] [CrossRef]
- El-tahlawy, K.F.; El-Bendary, M.A.; Elhendawy, A.G.; Hudson, S.M. The antimicrobial activity of cotton fabrics treated with different crosslinking agents and chitosan. Carbohydr. Polym. 2005, 60, 421–430. [Google Scholar] [CrossRef]
- Cao, X.L.; Cheng, C.; Ma, Y.L.; Zhao, C.S. Preparation of silver nanoparticles with antimicrobial activities and the researches of their biocompatibilities. J. Mater. Sci. Mater. Med. 2010, 21, 2861–2868. [Google Scholar] [CrossRef] [PubMed]
- Wei, D.; Sun, W.; Qian, W.; Ye, Y.; Ma, X. The synthesis of chitosan-based silver nanoparticles and their antibacterial activity. Carbohydr. Res. 2009, 344, 2375–2382. [Google Scholar] [CrossRef]
- Rezazadeh, N.H.; Buazar, F.; Matroodi, S. Synergistic effects of combinatorial chitosan and polyphenol biomolecules on enhanced antibacterial activity of biofunctionalized silver nanoparticles. Sci. Rep. 2020, 10, 19615. [Google Scholar] [CrossRef] [PubMed]
- Nithya, A.; JeevaKumari, H.L.; Rokesh, K.; Ruckmani, K.; Jeganathan, K.; Jothivenkatachalam, K. A versatile effect of chitosan-silver nanocomposite for surface plasmonic photocatalytic and antibacterial activity. J. Photochem. Photobiol. B Biol. 2015, 153, 412–422. [Google Scholar] [CrossRef] [PubMed]
- Mollick, S.; Islam, T.; Miah, R.; Riad, M.H.; Chakrabarty, T.; Hossen, T.; Islam, T. Development of Antibacterial Cotton Fabric Utilizing Microencapsulation Technique from Dragon Fruit Peel Extract. Fibers Polym. 2023, 24, 3937–3945. [Google Scholar] [CrossRef]
- Safi, M.; Gheisar, F.; Najafi, F.; Hadavand, B.S. Investigation of Shade Darkening Property of Polydimethylsiloxane and Poly (Dimethyl/Diphenyl Siloxane) Modified with Amino Groups on Dyed Textiles. Fibers Polym. 2023, 24, 4213–4227. [Google Scholar] [CrossRef]
- Emam, H.E.; Rehan, M.; Mashaly, H.M.; Ahmed, H.B. Large scaled strategy for natural/synthetic fabrics functionalization via immediate assembly of AgNPs. Dye. Pigment. 2016, 133, 173–183. [Google Scholar] [CrossRef]
- Rai, S.; Saremi, R.; Sharma, S.; Minko, S. Environment-friendly nanocellulose-indigo dyeing of textiles. Green Chem. 2021, 23, 7937–7944. [Google Scholar] [CrossRef]

| Samples | Washing Cycles | E. coli | S. aureus | ||
|---|---|---|---|---|---|
| Percent Reduction | Log 10 Reduction | Percent Reduction | Log 10 Reduction | ||
| Control | 0 | 0 | 0 | 0 | 0 |
| A34 | 0 | 100 | >6 | 100 | >6 |
| 25 | 100 | >6 | 100 | >6 | |
| 50 | 99.88 | 2.927 | 99.81 | 2.723 | |
| AgMP034 | 0 | 100 | >6 | 100 | >6 |
| 25 | 100 | >6 | 100 | >6 | |
| 50 | 100 | >6 | 100 | >6 | |
| 75 | 100 | >6 | 100 | >6 | |
| SS26 | 0 | 100 | >6 | 100 | >6 |
| 25 | 100 | >6 | 100 | >6 | |
| 50 | 100 | >6 | 100 | >6 | |
| 75 | 100 | >6 | 100 | >6 | |
| Samples | Washing Cycles | E. coli MG1655 | ESBL | ||
|---|---|---|---|---|---|
| Percent Reduction | Log 10 Reduction | Percent Reduction | Log 10 Reduction | ||
| Control | 0 | 0 | 0 | 0 | 0 |
| A34 | 0 | 99.971 | >3 | 99.99 | >4 |
| 25 | 99.976 | >3 | 99.99 | >4 | |
| Samples | L* | a* | b* | ΔE |
|---|---|---|---|---|
| Untreated cotton | 95.73 ± 0.10 | 1.01 ± 0.19 | −3.95 ± 1.44 | 0.52 ± 0.23 |
| SS26-0x | 79.27 ± 0.39 | 2.85 ± 0.34 | 5.21 ± 0.39 | 0.96 ± 0.38 |
| SS26-25x | 87.63 ± 0.75 | 2.56 ± 0.36 | 7.29 ± 1.14 | 1.45 ± 0.56 |
| SS26-50x | 90.24 ± 0.22 | 1.69 ± 0.05 | 5.43 ± 0.68 | 0.99 ± 0.55 |
| SS26-75x | 92.52 ± 0.26 | 0.53 ± 0.13 | 4.83 ± 0.27 | 0.59 ± 0.21 |
| Samples | L* | a* | b* | ΔE |
|---|---|---|---|---|
| Untreated cotton | 95.73 ± 0.10 | 1.01 ± 0.19 | −3.95 ± 1.44 | 0.52 ± 0.23 |
| AgMP034-0x | 82.24 ± 0.38 | 2.41 ± 0.18 | 9.97 ± 1.30 | 1.91 ± 1.01 |
| AgMP034-25x | 88.71 ± 0.20 | 1.73 ± 0.29 | 5.59 ± 1.30 | 1.51 ± 0.71 |
| AgMP034-50x | 90.54 ± 0.62 | 0.76 ± 0.05 | 5.94 ± 0.42 | 1.12 ± 0.42 |
| AgMP034-75x | 93.13 ± 0.18 | 0.24 ± 0.07 | 3.89 ± 0.29 | 0.51 ± 0.20 |
Disclaimer/Publisher’s Note: The statements, opinions and data contained in all publications are solely those of the individual author(s) and contributor(s) and not of MDPI and/or the editor(s). MDPI and/or the editor(s) disclaim responsibility for any injury to people or property resulting from any ideas, methods, instructions or products referred to in the content. |
© 2024 by the authors. Licensee MDPI, Basel, Switzerland. This article is an open access article distributed under the terms and conditions of the Creative Commons Attribution (CC BY) license (https://creativecommons.org/licenses/by/4.0/).
Share and Cite
Mirmohammadsadeghi, S.; Juhas, D.; Parker, M.; Peranidze, K.; Van Horn, D.A.; Sharma, A.; Patel, D.; Sysoeva, T.A.; Klepov, V.; Reukov, V. The Highly Durable Antibacterial Gel-like Coatings for Textiles. Gels 2024, 10, 398. https://doi.org/10.3390/gels10060398
Mirmohammadsadeghi S, Juhas D, Parker M, Peranidze K, Van Horn DA, Sharma A, Patel D, Sysoeva TA, Klepov V, Reukov V. The Highly Durable Antibacterial Gel-like Coatings for Textiles. Gels. 2024; 10(6):398. https://doi.org/10.3390/gels10060398
Chicago/Turabian StyleMirmohammadsadeghi, Seyedali, David Juhas, Mikhail Parker, Kristina Peranidze, Dwight Austin Van Horn, Aayushi Sharma, Dhruvi Patel, Tatyana A. Sysoeva, Vladislav Klepov, and Vladimir Reukov. 2024. "The Highly Durable Antibacterial Gel-like Coatings for Textiles" Gels 10, no. 6: 398. https://doi.org/10.3390/gels10060398
APA StyleMirmohammadsadeghi, S., Juhas, D., Parker, M., Peranidze, K., Van Horn, D. A., Sharma, A., Patel, D., Sysoeva, T. A., Klepov, V., & Reukov, V. (2024). The Highly Durable Antibacterial Gel-like Coatings for Textiles. Gels, 10(6), 398. https://doi.org/10.3390/gels10060398

